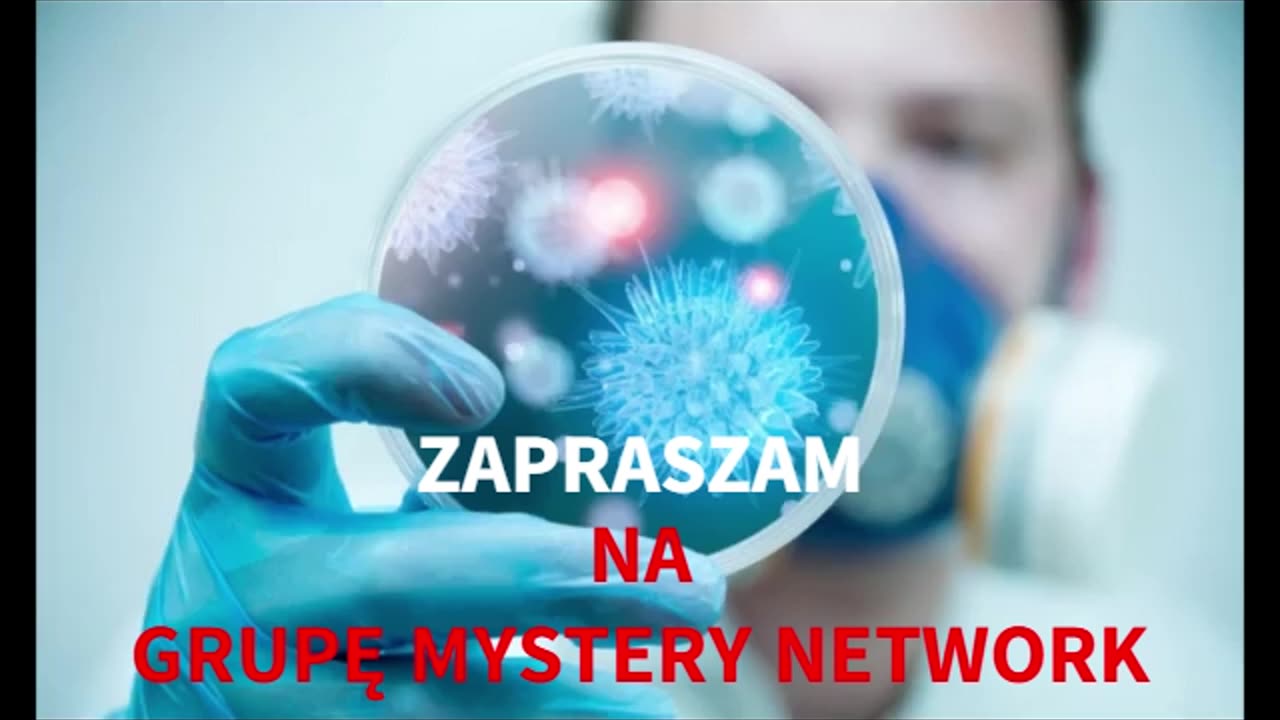

Premium Only Content
This video is only available to Rumble Premium subscribers. Subscribe to
enjoy exclusive content and ad-free viewing.
Wajrus 19-C ;)
6 months ago
Zbieramy na program do dubbingu https://buycoffee.to/obudzeni.tv
Dzięki programowi będziemy mogli tłumaczyć więcej filmów anglojęzycznych na język polski.
Loading comments...
-
 LIVE
LIVE
Side Scrollers Podcast
1 day ago🔴SIDE SCROLLERS SUB-A-THON🔴FINAL DAY!🔴Craig Makeover + US Dart Throw + More!
1,249 watching -
 LIVE
LIVE
Man in America
11 hours agoThe BRICS War on the Dollar Just Hit Endgame—What's Next Changes EVERYTHING
437 watching -
 47:41
47:41
Sarah Westall
2 hours agoNew Actions by Insiders Never Seen in History – Bitcoin Moves Ahead w/ Andy Schectman
4.02K1 -
 1:06:41
1:06:41
MattMorseTV
3 hours ago $24.46 earned🔴Trump PREPARES for WAR with VENEZUELA.🔴
17.7K35 -
 1:08:26
1:08:26
Glenn Greenwald
4 hours agoGlenn Takes Your Questions on Bill Ackman's Meddling in the NYC Election, Dems' Refusal to Endorse Zohran; MAGA Abandoning "America First," and More | SYSTEM UPDATE #537
87.2K24 -
 LIVE
LIVE
SOLTEKGG
2 hours ago🔴LIVE - Community Game Night - GIVEAWAY
108 watching -
 LIVE
LIVE
SpartakusLIVE
4 hours ago#1 Friday Night HYPE, viewers GLUED to the screen
146 watching -
 3:48:54
3:48:54
Nerdrotic
7 hours ago $23.65 earnedStar Wars is DEAD! | Is Hollywood Killing Pop Culture | WB for sale - Friday Night Tights 377
76.4K7 -
 LIVE
LIVE
SynthTrax & DJ Cheezus Livestreams
23 hours agoFriday Night Synthwave 80s 90s Electronica and more DJ MIX Livestream Electronic Favorites Edition
116 watching -
 39:10
39:10
BonginoReport
11 hours agoPro-Life Journo Attacked In Lawless NYC - Nightly Scroll w/ Hayley Caronia (Ep.163)
84.5K24